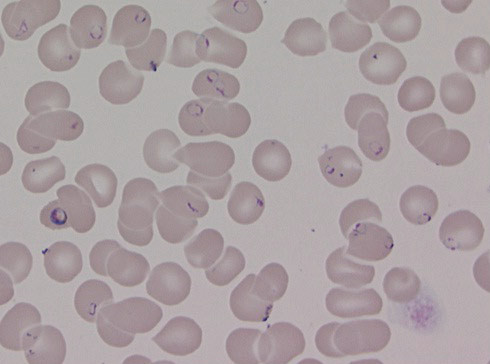
Figur 1  Tynndr&aring;peutstryk som viser h&oslash;y parasittemi hos pasient med alvorlig falciparummalaria. Rask behandling vil v&aelig;re&hellip;

HOVEDBUDSKAP
P. falciparum-malaria er en akutt og raskt livstruende infeksjon
Hurtigtest for malariadiagnostikk bør være tilgjengelig ved alle norske sykehus
Artesunat er førstevalg i behandling av alvorlig malaria og bør være tilgjengelig ved alle norske sykehus
Malaria er et av de største helseproblemene i verden, med 207 millioner estimerte sykdomstilfeller i 2012 (1). Antallet dødsfall er usikkert på grunn av mangelfull diagnostikk og rapportering, men det har vært estimert til mellom 473 000 og 1,2 millioner per år. Av disse finner mer enn 80 % sted i Afrika sør for Sahara (1, 2).
I Europa ble det av European Centre for Disease Control and Prevention (ECDC) registrert 5 482 malariatilfeller i 2011 (3). De rammede var hovedsakelig smittet i Afrika sør for Sahara og i Sørøst-Asia. Importert malaria skyldes hyppigst den potensielt maligne Plasmodium falciparum, og ifølge tall fra det globale overvåkingssystemet for reiserelaterte infeksjonssykdommer (GeoSentinel) utgjorde falciparummalaria 5 % av 17 228 reiserelaterte sykdomstilfeller i 2009 (4). I vår tid er smitte i Europa svært uvanlig, men i 2011 ble det rapportert 61 tilfeller av vivaxmalaria smittet i Hellas (3).
I Norge er det i perioden 2004 – 13 blitt meldt 28 – 88 malariatilfeller årlig til Meldingssystem for smittsomme sykdommer (MSIS) (5). Flest var det i 2013, med 88 tilfeller fordelt på 18 av landets 19 fylker. Nord-Trøndelag var det eneste fylket det ikke ble meldt malariatilfeller fra. Til sammenlikning er det i samme periode blitt meldt 27 – 48 tilfeller av systemisk meningokokksykdom (5). Så mye som 57 – 75 % av malariatilfellene som blir diagnostisert i Norge er forårsaket av P. falciparum (5).
Som profylakse ved reise til malariaområder anbefales vanligvis atovakvon-proguanil eller meflokin. I Norge ble det i 2012 ifølge tall fra Reseptregisteret skrevet ut 23 787 resepter på atovakvon-proguanil og 4 011 resepter på meflokin (6). Det siste tiåret har det vært en gradvis økning i forskrivningen av atovakvon-proguanil årlig, med 8 430 flere resepter i 2012 enn i 2005, mens antallet resepter på meflokin årlig har vært uendret.
I Norge er afrikanske innvandrere den gruppen som hyppigst pådrar seg malaria, trolig fordi de ofte reiser til endemiske områder uten forebyggende tiltak (7). Vår erfaring er at mennesker med opprinnelse fra malariaendemiske områder opplever sykdommen som plagsom, men sjelden som farlig, på grunn av immunitet, og tenker ikke over at de har mistet sin malariaimmunitet. Også turister, utstasjonerte og andre reisende står i fare for å bli smittet. Det er derfor viktig å være oppmerksom på risikoen for malaria i alle grupper av befolkningen (7).
Symptomene på malaria er uspesifikke i tidlig fase, og kan feiltolkes som influensa, gastroenteritt eller annen akutt febersykdom med allmennsymptomer i form av kvalme, oppkast, diaré, hodepine, ryggsmerter, muskelsmerter eller hoste (8).
Ved falciparummalaria eller ved den sjeldne malariaformen som skyldes Plasmodium knowlesi kan tilstanden raskt utvikle seg til alvorlig sykdom der øyeblikkelig behandling kan være livreddende. En pasient med malaria som er allment påvirket i den forstand at vedkommende ikke er i stand til å svelge tabletter, har tegn på dysfunksjon fra vitale organer eller høy parasittemi (> 2 – 4 %) har alvorlig malaria (8). Gravide og små barn har spesielt høy risiko for raskere utvikling og alvorligere forløp av sykdommen (9).
Malaria diagnostiseres ved hjelp av giemsafarget tynn- og tykkdråpe blodutstryk med påvisning av plasmodiumart og parasittemi (prosent røde blodceller som er infisert). Antigentester er et supplement som raskt kan avklare om pasienten har malaria og bør derfor være tilgjengelig ved alle sykehus, spesielt ved sykehus der man er uten kompetanse innenfor malariamikroskopi. Det finnes mange ulike malariahurtigtester med varierende sensitivitet og spesifisitet (10). Generelt har samtlige tester lavere sensitivitet for andre arter enn P. falciparum.
Pasienter med mistenkt malaria må uten forsinkelse få utført en test. Ved påvist falciparummalaria skal pasienten behandles og overvåkes i sykehus der medikamenter til intravenøs behandling ved eventuelt alvorlig forløp må være tilgjengelige. En detaljert anbefaling for behandling av malaria i Norge er tidligere publisert i Tidsskriftet (11) og i Nasjonal faglig retningslinje for bruk av antibiotika i sykehus, utgitt av Helsedirektoratet i 2013 (12).
Formålet med denne studien var å undersøke beredskap og rutiner for diagnostikk og behandling av malaria ved norske sykehus.
Materiale og metode
Vi gjorde en spørreundersøkelse i tidsrommet oktober 2012 – august 2014. Den ble gjennomført ved hjelp av det nettbaserte verktøyet Questback ask & act (QuestBack Norge, Oslo, Norge). Vi tok kontakt per telefon med avdelingsoverlegene ved sykehus med en indremedisinsk funksjon eller med seksjonsoverlegene ved infeksjonsmedisinsk seksjon ved de sykehus der dette finnes. Totalt 48 sykehus ble kontaktet. Spørsmålene med svaralternativer fra spørreundersøkelsen er gjengitt i ramme 1.
Spørsmålene med svaralternativer
-
I
Hva blir brukt for å diagnostisere malaria ved din avdeling?
Mikroskopi av blodutstryk med tykkdråpe
Mikroskopi av blodutstryk med tynndråpe
Mikroskopi av blodutstryk med tykkdråpe og tynndråpe
Hurtigtest + mikroskopi av blodutstryk
Bare hurtigtest
Annet
-
II
Hvilke førstehåndspreparater har dere i beredskap ved deres sykehus til initial parenteral behandling av alvorlig/komplisert falciparummalaria?
Kinin intravenøst
Artesunat intravenøst
Annet
Svaralternativ «Annet» ga mulighet for å skrive fritekst i tekstboks, de øvrige svaralternativene hadde rubrikk for avkrysning
Transporttid mellom sykehus ble undersøkt ved hjelp av Google Maps.
I tilfeller der det var tvil om svarene rapportert på det elektroniske spørreskjemaet, ble sykehuset kontaktet per telefon for avklaring. Det ble sendt gjentatte purringer ved manglende svar. Studien ble forelagt regional etisk komité, som vurderte at det ikke var nødvendig med godkjenning.
Resultater
Av de 48 sykehusene som ble kontaktet, var det først avdelings- eller seksjonsoverleger ved 38 som besvarte det elektroniske spørreskjemaet. I ettertid ble det samlet inn svar fra overleger ved de ti resterende sykehusene per telefon, slik at det foreligger svar fra samtlige sykehus som potensielt kan møte malariapasienter i Norge. I tillegg er sykehusene som rapporterte at de ikke hadde medikamenter i beredskap blitt kontaktet med tanke på om det har vært forandringer i malariaberedskapen.
Så mange som 40 % (19/48) rapporterte at de ikke har medikamenter for alvorlig malaria tilgjengelig. Fra 13 sykehus ble det kommentert at de ville ha sendt malariapasientene videre til et annet sykehus, to ville få tilsendt medikamenter fra et annet sykehus, mens fire rapporterte at de ikke hadde medikamenter for behandling av alvorlig malaria tilgjengelig – uten nærmere angivelse av plan for behandling hvis aktuelt.
Resultater for rapportert tilgjengelig diagnostikk og behandling av alvorlig malaria ved norske sykehus er fremstilt i tabell 1.
Tabell 1
Diagnostiske metoder og medikamenter til behandling av alvorlig malaria tilgjengelig ved norske sykehus basert på en nasjonal spørreundersøkelse (n = 48)
| Antall |
(%) |
|
| Diagnostiske metoder |
||
| Hurtigtest og mikroskopi tilgjengelig |
31 |
(65) |
| Bare mikroskopi tilgjengelig |
13 |
(27) |
| Bare hurtigtest tilgjengelig |
1 |
(2) |
| Ingen diagnostiske metoder tilgjengelig |
3 |
(6) |
| Medikamenter |
||
| Kun artesunat til intravenøst bruk tilgjengelig |
13 |
(27) |
| Kun kinin til intravenøst bruk tilgjengelig |
13 |
(27) |
| Både artesunat og kinin til intravenøst bruk tilgjengelig |
3 |
(6) |
| Verken artesunat eller kinin til intravenøst bruk tilgjengelig |
19 |
(40) |
Av sykehus uten artesunat eller kinin tilgjengelig (n = 19) hadde så mange som 11 mer enn to timers reisevei til nærmeste sykehus med beredskap. Tre av disse hadde heller ikke diagnostikk tilgjengelig. Tabell 2 viser tilgjengelig diagnostikk samt transporttid med bil til nærmeste sykehus med beredskap, for sykehus uten artesunat eller kinin tilgjengelig.
Tabell 2
Diagnostiske metoder tilgjengelig og transporttid med bil til referansesykehus for sykehus som ikke har artesunat eller kinin tilgjengelig (n = 19). Data angir antall sykehus
| Transporttid (min) |
|||||
| Sykehus uten medikamentell beredskap |
< 60 |
60 – 120 |
121 – 480 |
Totalt |
|
| Totalt antall sykehus |
2 |
6 |
11 |
19 |
|
| Hurtigtest og mikroskopi tilgjengelig |
2 |
4 |
2 |
8 |
|
| Bare mikroskopi tilgjengelig |
0 |
2 |
6 |
8 |
|
| Bare hurtigtest tilgjengelig |
0 |
0 |
0 |
0 |
|
| Ingen diagnostiske metoder tilgjengelig |
0 |
0 |
3 |
3 |
|
Diskusjon
Malaria er en øyeblikkelig hjelp-tilstand der det har vært en økning i antall tilfeller rapportert til MSIS de siste par årene. Pålitelig diagnostikk og effektive medikamenter bør være tilgjengelig ved alle norske sykehus for at man skal kunne forhindre dødsfall (5, 13). Denne undersøkelsen avdekker mangler i akuttberedskapen for diagnostikk og behandling av alvorlig malaria i Norge. Tre sykehus har ikke diagnostiske metoder tilgjengelig og 40 % har ikke beredskap for å gi akuttbehandling ved alvorlig malaria.
Mikroskopi krever erfaring med metoden og er nødvendig for å kunne vurdere grad av parasittemi og dermed alvorlighetsgrad samt gjøre sikker artsbestemmelse (fig 1) (14). Ved sykehus hvor det ikke finnes kompetanse til å utføre mikroskopisk undersøkelse 24 timer i døgnet, bør man ha tilgjengelig hurtigtester for antigenpåvisning, noe som kan gjøres i påvente av mikroskopisk undersøkelse. For sykehus som har mikroskopi, men ikke hurtigtest tilgjengelig, er døgnberedskap en forutsetning. Det er mindre sannsynlig at alle små lokalsykehus har døgnberedskap, og disse vil ha størst nytte av hurtigtester. Disse testene er enkle å utføre og anbefales som et minimum for malariadiagnostikk for alle sykehus i Norge.
Artesunat er et effektivt malariamiddel, med lite bivirkninger. Det er i randomiserte studier vist at det gir høyere overlevelse enn kinin, og det anbefales som førstevalg i behandling av alvorlig falciparummalaria (11, 12, 15) – (17). Kinin er et alternativ til artesunat ved de sykehusene som kun har dette tilgjengelig, men det kan, i tillegg til å ha langsommere innsettende effekt, gi bivirkninger som arytmi, forlenget QT-tid, cinchonisme (øresus og svimmelhet) og hypoglykemi (17). Både artesunat og kinin må skaffes på registreringsfritak.
En pakke artesunat inneholdende seks enheter à 60 mg koster rundt 670 kroner. Dette medfører en kostnad på kun omkring 1 500 kroner for behandling av en voksen person. Holdbarheten er 2 – 3 år fra produksjonsdato. Kostnader ved antimikrobiell behandling anvendt på rett indikasjon vil alltid være berettiget ved alvorlige og livstruende infeksjonssykdommer (18).
Alvorlig malaria kan, hva gjelder hyppighet, alvorlighetsgrad og behov for spesialisthelsetjeneste, sammenliknes med akutt bakteriell meningitt, der man anbefaler antibiotika intravenøst innen en halvtime ved klinisk mistanke (12, 19). Som ved meningitt vil forsinkelse før oppstart av behandling av malaria forverre prognosen. Malariadødsfall i Europa skyldes overveiende forsinket diagnostikk og behandling (20, 21).
Det er bekymringsfullt at samtlige av de norske sykehusene som rapporterte at de ikke hadde medikamenter for behandling av alvorlig malaria tilgjengelig, var lokalsykehus der bare to av 19 hadde under en times transporttid til sykehus med beredskap. Bruk av ambulansefly og helikopter må antas å redusere transporttiden, men geografiske og meteorologiske forhold kan sette begrensninger for om slik transport til enhver tid er mulig (22).
Økningen som er registrert i forskrivningen av atovakvon-proguanil de siste ti årene skyldes sannsynligvis i hovedsak at nordmenn i økende grad reiser til malariaendemiske områder, selv om noe også kan skyldes at flere beskytter seg mot malaria ved reiser eller økende bruk av langtidsprofylakse. I 2013 ble malaria diagnostisert i 18 fylker i landet, hvilket illustrerer at leger ved ethvert sykehus i Norge risikerer å stå overfor en feberpasient som viser seg å ha malaria.
Vi fant at enkelte sykehus der man ikke har medikamenter tilgjengelig, har god beredskap for å overflytte pasienter til annet sykehus, slik at behandlingsforsinkelsen er liten og denne oppveies av fordelen ved å sentralisere behandlingen. Men undersøkelsen avdekker at mer enn en tredel av norske sykehus ikke kan gi akuttbehandling til pasienter med alvorlig malaria, hvilket utgjør økt risiko for dødelig forløp av denne sykdommen.
- 1.
World malaria report. Genève: WHO, 2013.
- 3.
European Centre for Disease Prevention and Control. www.ecdc.europa.eu/en/publications/Publications/annual-epidemiological-report-2013.pdf (25.9.2014).
- 5.
MSIS. Folkehelseinstituttet. www.msis.no (25.9.2014).
- 6.
Reseptregisteret 2005 – 2012. www.reseptregisteret.no (25.9.2014).
- 7.
Smittevernboka. Oslo: Folkehelseinstituttet, 2013. www.fhi.no/ eway/default.aspx?pid=239&trg=Content_6493&Main_6157=6287:0:25,5499& MainContent_6287=6493:0:25,6833&Content_6493=6441:82817::0:6446:77:::0:0 (25.9.2014).
- 8.
Severe falciparum malaria. World Health Organization, Communicable Diseases Cluster. Trans R Soc Trop Med Hyg 2000; 94 (suppl 1): S1 – 90. [PubMed]
- 10.
Malaria rapid diagnostic tests performance, round 5. Genève: WHO, 2013.
- 11.
Mørch K, Myrvang B. Medikamentell behandling av malaria i Norge. Tidsskr Nor Legeforen 2012; 132: 664 – 7. [PubMed]
- 12.
Nasjonal faglig retningslinje for bruk av antibiotika i sykehus. Oslo: Helsedirektoratet, 2013.
- 17.
Guidelines for the treatment of malaria. 2 utg. Genève: WHO, 2010.
- 18.
Helsedirektoratet. Kostnadsvurderinger. http://helsedirektoratet.no/sites/antibiotikabruk-i-sykehus/generelle-kapitler/kostnadsvurderinger/Sider/default.aspx (25.9.2014).
- 19.
Skrede S, Sjursen H, Solberg CO. Behandling av akutt bakteriell meningitt. Tidsskr Nor Lægeforen 2001; 121: 3306 – 9. [PubMed]
- 22.
Haug B, Åvall A, Monsen S-A. Luftambulansens pålitelighet – en undersøkelse i tre kommuner på Helgeland. Tidsskr Nor Legeforen 2009; 129: 1089 – 93. [PubMed]